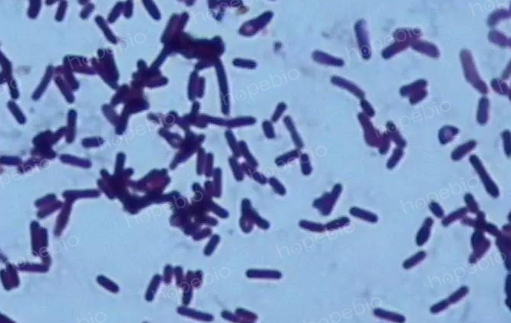
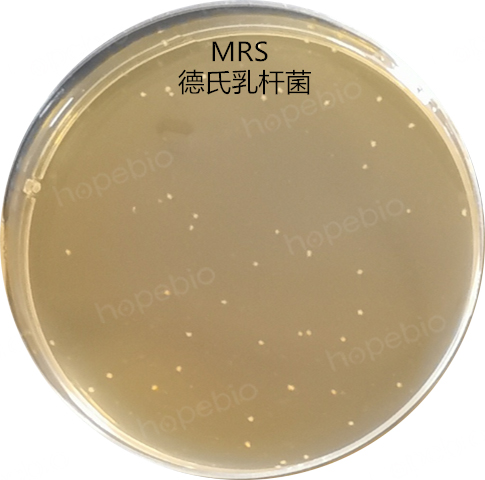
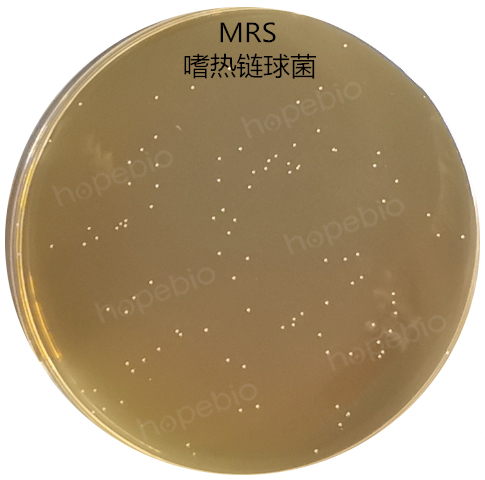
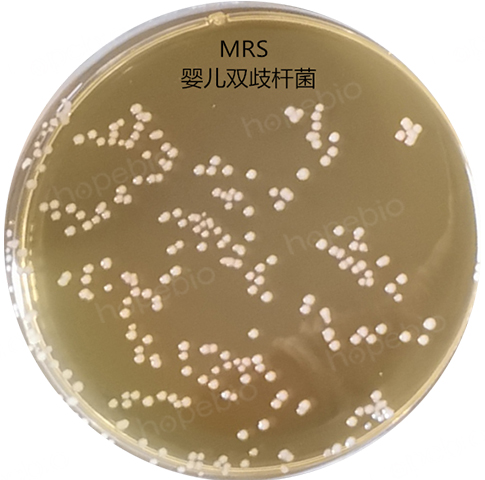
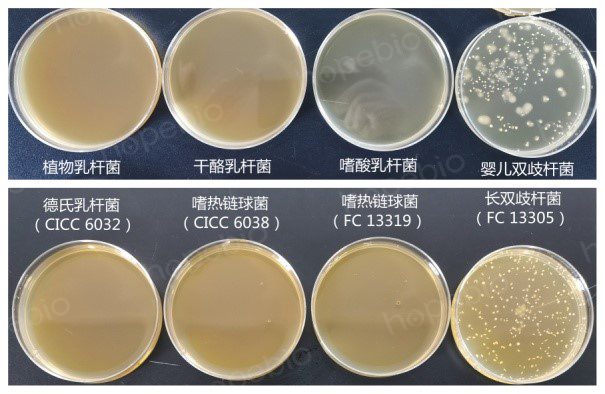
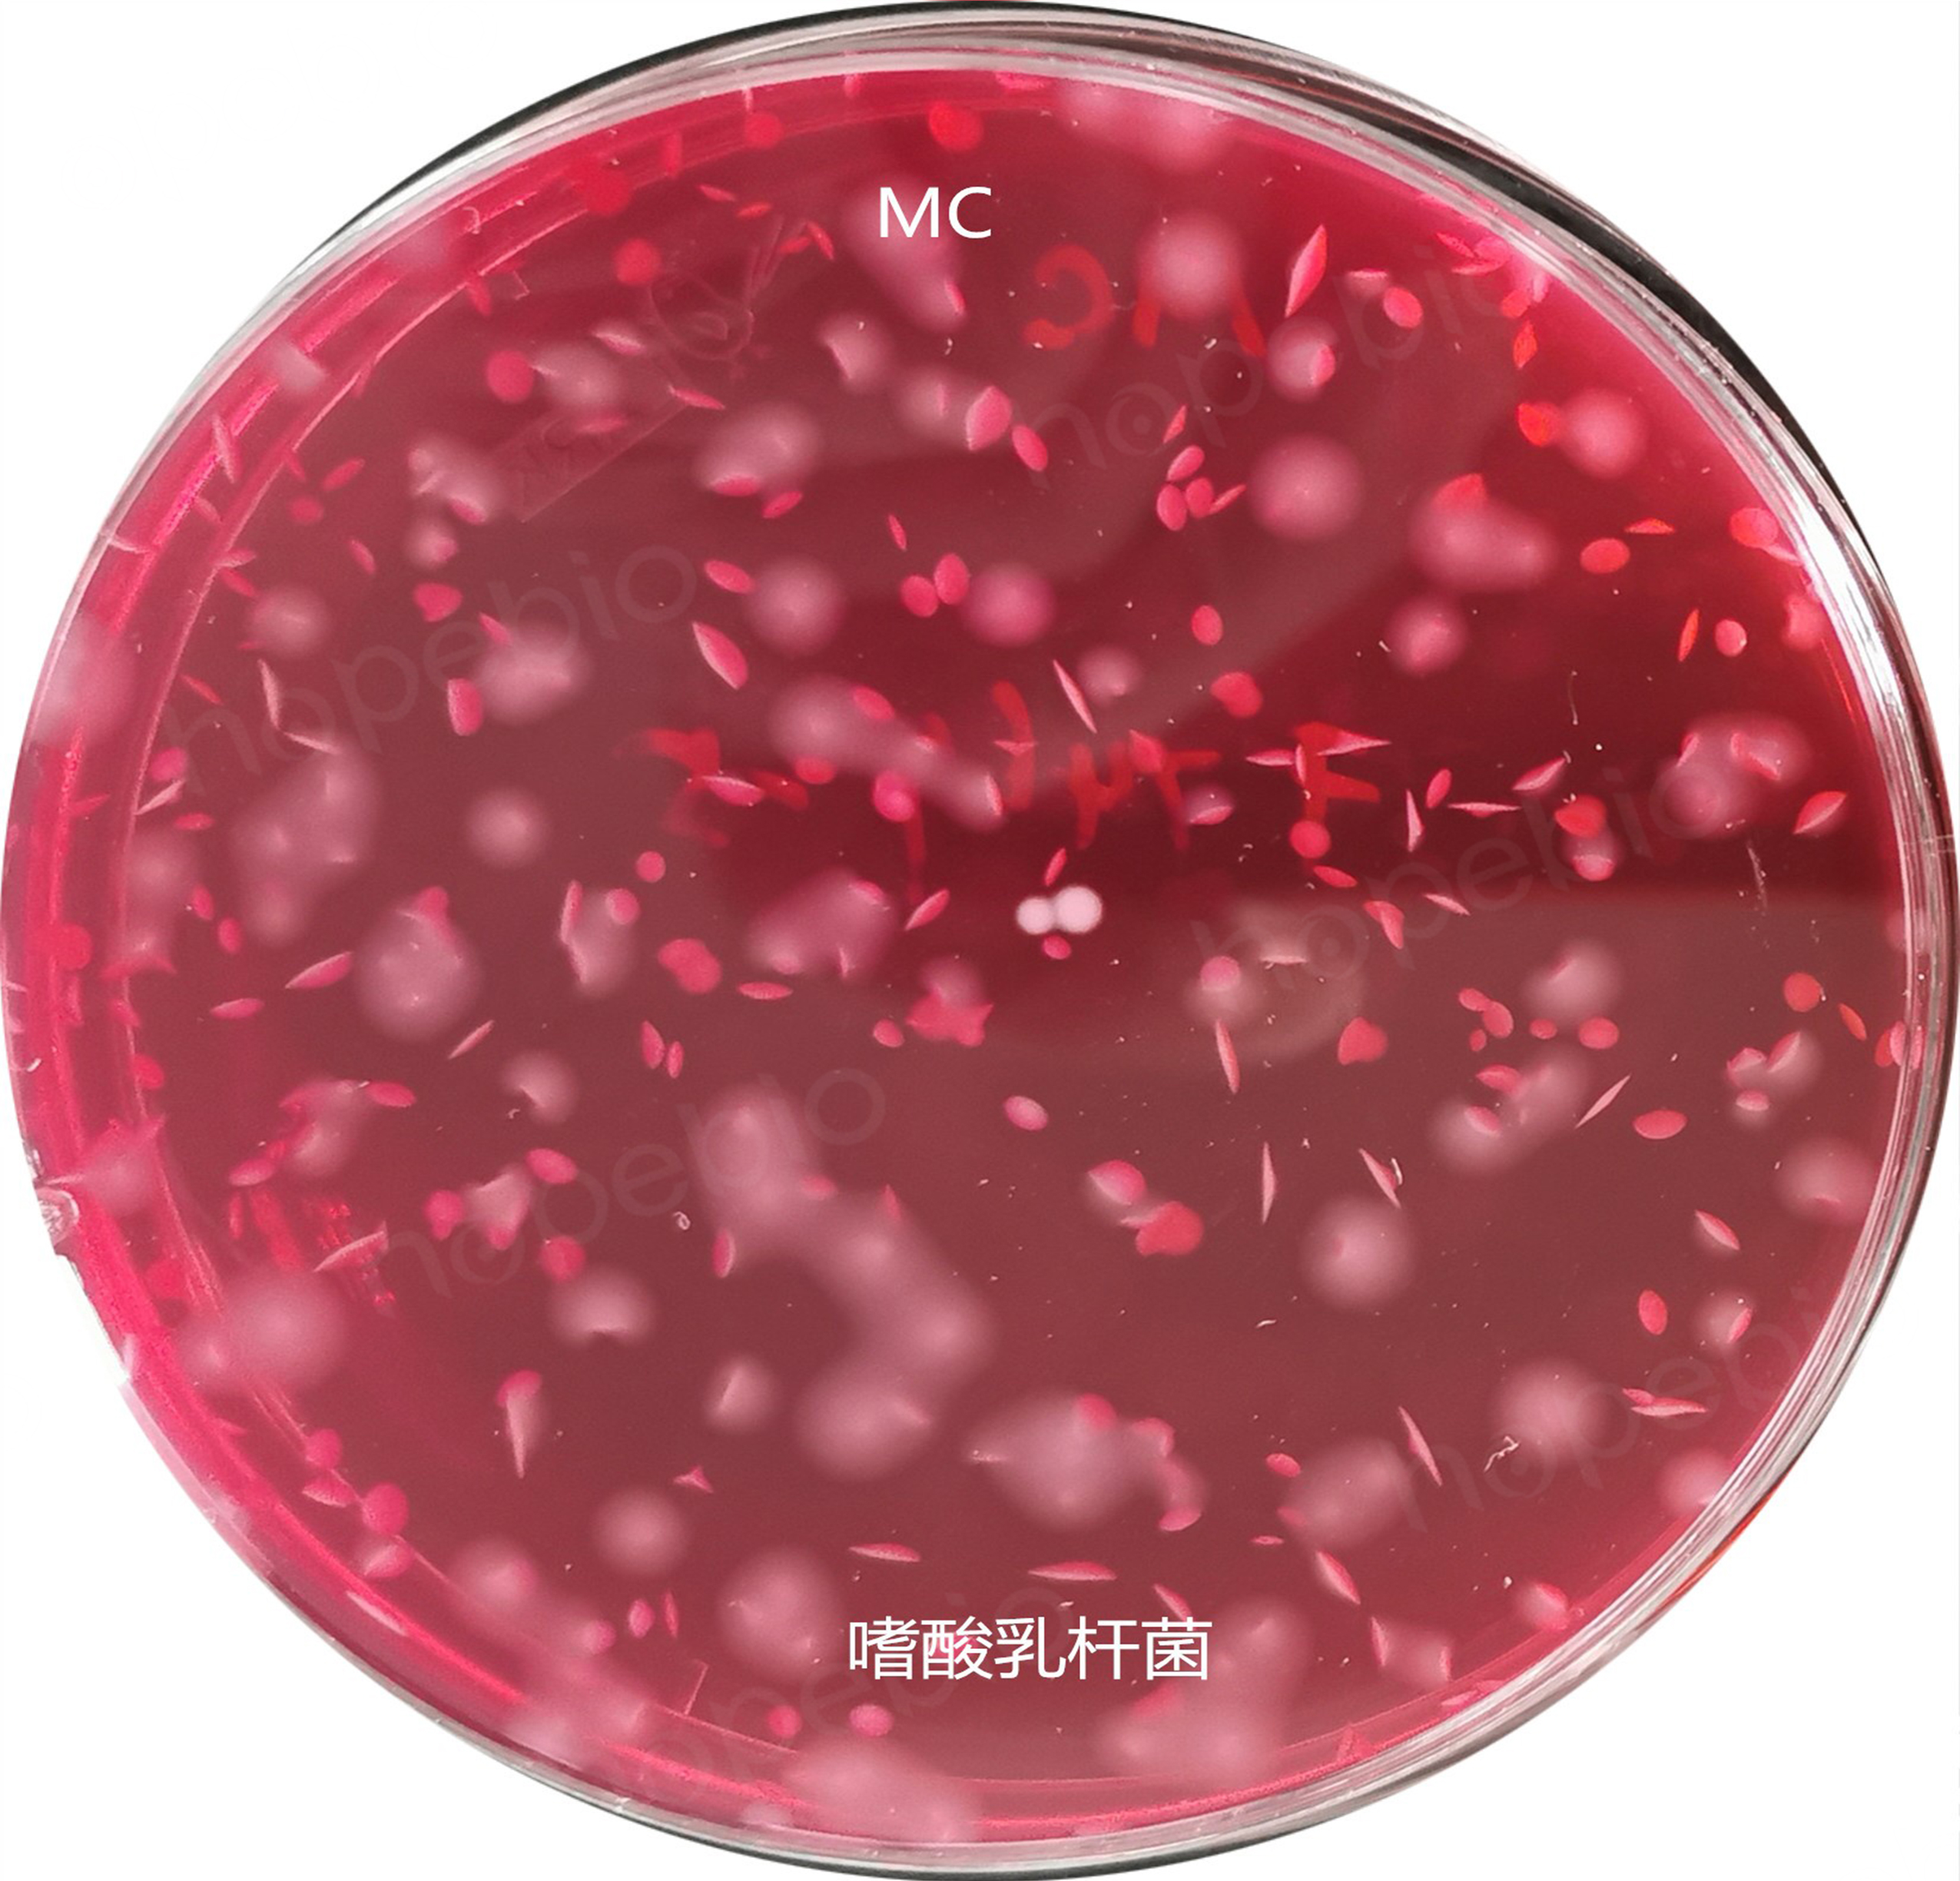
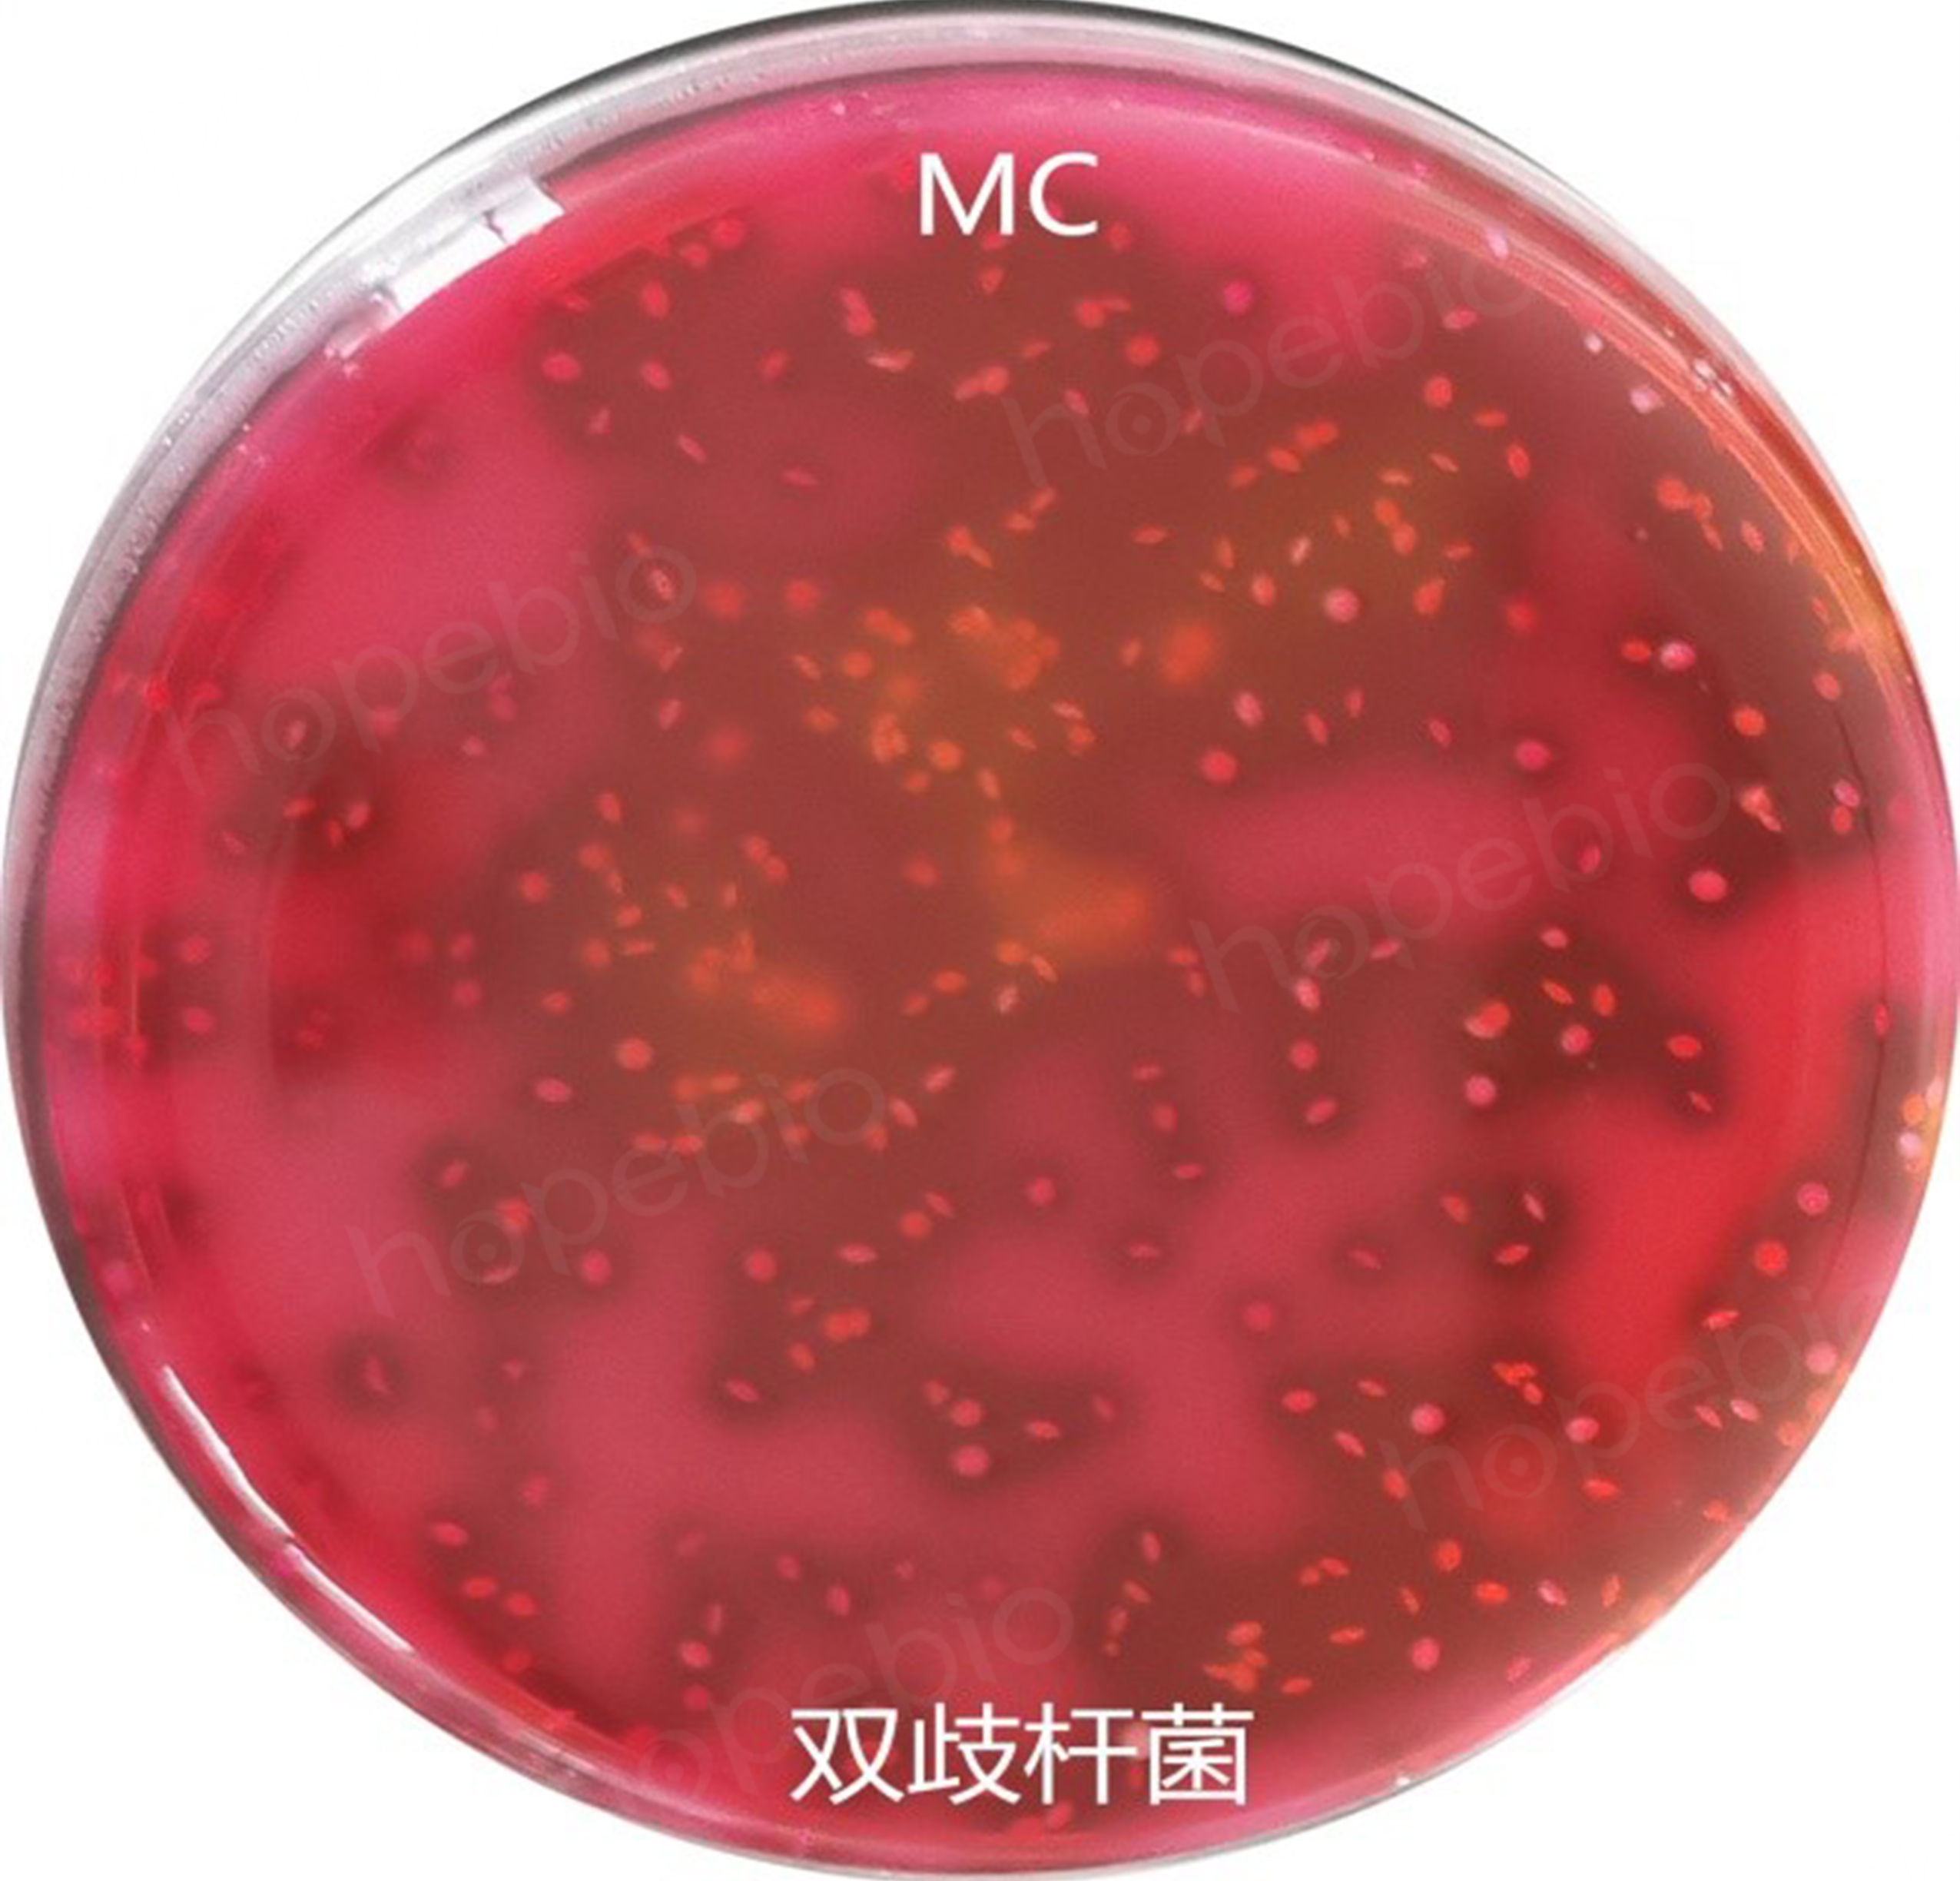

海博微信公众号
海博天猫旗舰店




乳杆菌属菌体形态多样,呈长杆状、弯曲杆状或短杆状(图1)。

双歧杆菌呈短杆状、纤细杆状或球形,可形成各种分支或分叉等多形态,如Y字形、v字形、弯曲状、勺形(图2),典形形态为分叉杆菌,因而取名bifidus,不抗酸,无动力。


嗜热链球菌菌体呈球形、卵圆形或球杆状,直径为0.5μm~2.0μm,成对或成链排列(图3)。


图3 嗜热链球菌的显微形态
《GB4789.35-2016食品安全国家标准 食品微生物学检验 乳酸菌检验》中规定,乳酸菌的检验程序如下:

图4 乳酸菌检验程序
该检验程序中,共涉及3种培养基,本文将对它们分别进行详细阐述。
培养基成分(g/L)如下:
蛋白胨
10.0
牛肉浸粉
5.0
酵母浸粉
4.0
葡萄糖
20.0
磷酸氢二钾
2.0
柠檬酸三铵
2.0
醋酸钠
5.0
硫酸镁
0.2
硫酸锰
0.05
琼脂
15.0
吐温80
1.0
pH值6.2±0.2
25℃
表1 MRS培养基上各质控菌株的生长情况要求

图5 MRS琼脂上各质控菌株的生长状态
莫匹罗星是一种抗生素,主要用于杀灭皮肤表面的革兰氏阳性球菌,对一些革兰氏阴性细菌有一定的抗菌作用(图6)。加入本培养基中,可以抑制乳杆菌和嗜热链球菌等杂菌的生长。


L-半胱氨酸是一种具有生理功能、在自然界广泛存在的重要物质。它在动植物体内是各组织细胞用来防御有害物质和增加活力的一种氨基酸,并且是唯一具有活性巯基(-SH)的氨基酸,具有促进蛋白质合成、刺激生长、增加脂肪分解、增强免疫的作用,添加在该产品中,可以使培养基维持较低的氧化还原电位,促进厌氧菌双歧杆菌的生长(图7)。


表2 改良MRS培养基上各质控菌株的生长情况要求

图8 改良MRS培养基上各质控菌株的生长状态
3、MC琼脂培养基:成分(g/L)如下 :
大豆蛋白胨
5.0
牛肉浸粉
3.0
酵母浸粉
3.0
葡萄糖
20.0
乳糖
20.0
碳酸钙
10.0
琼脂
15.0
中性红
0.05
pH值6.0±0.1
25℃
表3 MC琼脂上各质控菌株生长的要求

菌种
碳水化合物
七叶苷
纤维二糖
麦芽糖
甘露醇
水杨苷
山梨醇
蔗糖
棉子糖
植物乳杆菌
+
+
+
+
+
+
+
+
干酪乳杆菌
+
+
+
+
+
+
+
-
德氏乳杆菌
-
-
-
-
-
-
-
-
表5 常见嗜热链球菌的主要生化反应
菌种
菊糖
乳糖
甘露醇
水杨苷
山梨醇
马尿酸
七叶苷
嗜热链球菌
-
+
-
-
-
-
-
表6 常见双歧杆菌的主要生化反应
菌种
碳水化合物
鼠李糖
甘露醇
山梨醇
七叶苷
水杨苷
纤维二糖
乳糖
蔗糖
棉子糖
葡萄糖
婴儿双歧杆菌
-
-
-
-
+
+
+
+
+
+
长双歧杆菌
-
-
-
+
-
-
+
+
+
+

图10 标准中对于生化反应符合性的备注说明
补充说明:
该标准涉及的内容较多,本次列出的是常规性的一些内容,有关计数方式和培养基的具体选择问题,将在后续的文章中继续探讨。
相关产品:
莫匹罗星锂盐和半胱氨酸盐酸盐改良MRS培养基-点击查看产品详情
相关标准:
注:本文属海博生物原创,未经允许不得转载。
